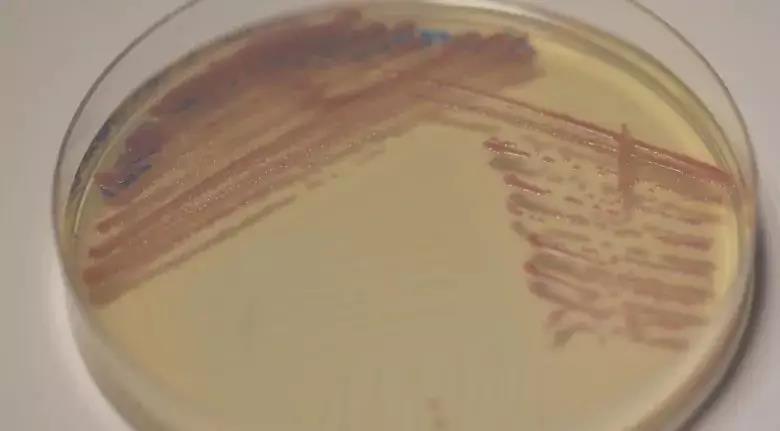

GAA:“超级细菌”无关食品安全,BAP标准将重新修订,某些抗生素将不允许使用
发布时间:2019-03-22 11:02:26 信息来源:UCN国际海产资讯 编辑:STAR

GAA反驳CBC,称加拿大虾产品中发现的抗药性细菌无关食品安全。 GAA表示将重新修订BAP认标准,未来一些抗生素将不允许在BAP认证养殖场继续使用。
文:Louis Harkell
译:胡路怡
近期,北美虾类营销又染上了负面新闻。加拿大媒体CBC新闻的一份调查显示,17%加拿大零售虾产品携带抗药大肠杆菌和金黄色葡萄球菌,其中两个样品被曝含有“超级细菌”,部分产品贴有BAP(最佳水产养殖规范)认证标签。
此事件成为本届波士顿展会上讨论的热门话题。
全球水产养殖联盟(GAA)主席George Chamberlain担心,这份报道可能误导加拿大的读者。“解决抗药性问题是整个食品行业的重要议题,这也是关乎到抗生素长期有效性的人类健康问题。”Chamberlain强调,“不过,这与食品安全问题是两回事,目前没有任何证据显示养殖对虾是不安全的。”
“过去二十年,美国从海外进口了大量虾产品,与养虾对虾有关的食源性疾病的报告发生率并没有增加,但在此期间,美国虾类消费数量却明显增多。”Chamberlain解释,“GAA下的BAP认证项目涉及到养殖场管理中的抗生素使用,和加工厂的抗生素残留检测,从加拿大零售商店内发现的细菌抗药性,比其他陆地蛋白内的抗药性都要低。”
“细菌可存在于各种食品中,高温可以杀死细菌。此外,即使煮熟的食品中含有细菌,也必须达到一定数量才可能致病。加拿大的研究没有说明细菌的具体浓度。”GAA称。
“另外,CBC也没法证明对虾样品产自使用过抗生素的养殖场。抗药性可能来源于土壤、水体或其他途径,我们也没有看到任何证据显示对虾样本有抗生素的残留。”GAA称。
美国国家渔业协会对虾分会主席Bill Dresser认为,CBC的报告有失公允,基于食品安全特性,海产品的表现优于其他动物蛋白。印度海产品出口协会秘书长Elias Sait称,2018年仅0.1%印度输美对虾因抗生素被拒。
两个虾样品中发现“超级细菌”-耐甲氧西林金黄色葡萄球菌(MRSA)(图片来源:CBC)
“细菌耐药性是个复杂的问题,人类医疗和所有的养殖业都使用过抗生素。”GAA发展总监Iain Shone表示,“2017年,GAA就参与了联合国的一项论坛会议,探讨如何对抗细菌的耐药性。当时,联合国卫生组织(WHO)、世界动物卫生组织(OIE)和联合国粮农组织(FAO)等提出了一系列建议,最终推送至联合国秘书长。”
“这些建议提到了水产养殖业。建议呼吁水产养殖业建立更好的诊断系统、改进的数据收集、提高生物安保,以减少对抗生素的需求。”Shone称,“人们越来越关注抗生素在动物健康领域的使用,特别是水产养殖业。我们很快就要面对这个问题。”
“今年,GAA将重新修订BAP标准,抗生素的使用将变得更加严格。新标准出台后,BAP认证的养殖场将不再允许使用某些抗生素。”Shone说。
声明:① 凡本网所有原始/编译文章及图片、图表的版权均属中国水产流通与加工协会所有,如要转载,需注明信息来源:中国水产流通与加工协会
② 凡本网注明信息来源:XXX(非中国水产流通与加工协会)的作品,均转载自其他媒体,转载目的在于传递更多的信息,并不代表本网赞同其观点和对其真实性负责。
※ 联系电话:010-65067637